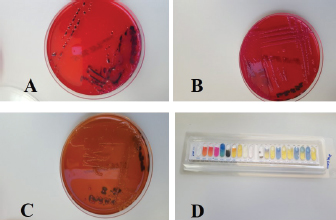

| Original Article | ||
Open Vet. J.. 2019; 9(3): 263-268 doi: 10.4314/ovj.v9i3.12 Open Veterinary Journal, (2019), Vol. 9(3): 263–268 Original Research DOI: http://dx.doi.org/10.4314/ovj.v9i3.12 Salmonella enterica and Theileria co-infection in dromedary camels (Camelus dromedarius) in UAEGhada Elderdiri Abdelwahab1, El Tigani-Asil1, Mohammed Farouk Yusof1, Zayed Saud Abdullah1, Jamal Fattah Rifat2, Mohamed A. Al Hosani1, Salama Suhail Almuhairi1 and Abdelmalik Ibrahim Khalafalla1*1Veterinary Laboratories Division, Animal Health Sector, Abu Dhabi Agriculture and Food Safety Authority (ADAFSA), Abu Dhabi, UAE 2Animal Health Division, Animal health Sector, Abu Dhabi Agriculture and Food Safety Authority (ADAFSA), Abu Dhabi, UAE *Corresponding Author: Abdelmalik Ibrahim Khalafalla. Animal Health Sector, Abu Dhabi Agriculture and Food Safety Authority (ADAFSA), Abu Dhabi, UAE. Email: abdelmalik.khalafalla [at] adfca.gov.abudhabi Submitted: 27/05/2019 Accepted: 08/08/2019 Published: 15/09/2019 © 2019 Open Veterinary Journal AbstractBackground: Despite a steady increase in camel husbandry worldwide, pathology of camel diseases is still relatively under-investigated. Clinical hematuria is generally indicative of either acute or chronic urogenital inflammations, traumatic calculous injuries, cancers, corrosive poisonings. Infectious agents are not typically implicated in urinary tract infection of camels. Aim: This study aims to explore possible causes in camels clinically suffered from acute febrile disease with severe hematuria. Methods: To achieve aims of the study culturing of urine samples, microscopic examination for detection of blood parasites, phenotypic and genotypic characterization for the identification of isolated bacteria were followed. Results: Conventional bacteriology enabled identification of Salmonella enterica subsp. enterica serovar typhimurium which further genotyped by 16S rRNA gene sequencing. Microscopic examination of Giemsa stained blood smears from both infected dromedary camels revealed the presence of pleomorphic Theileria piroplasms. The results suggest that the clinical symptoms were as coinfection induced by salmonellosis and theileriosis. Conclusion: Given these remarkable findings, further research should aim to better characterize the opportunistic pathogens associated with camel theileriosis, as well as to determine other possible infectious agents of the camel urinary tract. Keywords: Dromedary camel, Hematuria, Salmonella enterica, Theileriosis. IntroductionThe literature on camel diseases is scant in comparison to other important livestock species. In regions where husbandry is practiced, camels are known to suffer from several obscure fatal syndromes and diseases, the causes of which are not well understood (Abbas and Omer, 2005). Tick-borne diseases (TBD), including babesiosis, theileriosis, and anaplasmosis, remain a continual threat to domestic and wild ruminant breeding programs (Allison and Meinkoth, 2010). Salmonellosis is an animal disease with zoonotic potential, characterized by enteric or enterohepatic manifestations, which result in several clinical signs, including neonatal scours, abortion, orchitis, pneumonia, and septicemia (Yagoub, 2005; Gruenberg, 2018). Different Salmonella species are implicated in such cases of infection. Non-typhoidal salmonella infections have been reported to cause urinary tract infections in immunocompromised human patients (Allerberger et al., 1992; Gordon, 2008). To date, no previous studies have reported Salmonellosis of the urinary tract in camels; however, a previous study reported the isolation of Salmonella enteritidis from feces and mesenteric lymph nodes of healthy camels, noting that camels may act as a reservoir for this bacterium (Mohamed and Suelam, 2010). The studies have shown that the camel urine has an inhibitory effect against certain pathogenic bacteria, including Acinetobacter spp., Enterococcus faecalis, Pseudomonas aeruginosa, Haemophillus influenza, klebsiella spp., Escherichia coli, Streptococcus pneumoniae, Citrobacter spp., Morganella morganii, Providencia spp., Staphylococcus aureus, Micrococcus spp., Bacillus spp., and Salmonella spp. (Shoeib and Ba-hatheq, 2007; Humaid, 2016). The pathogenesis of salmonellosis begins with localized colonization of the bacteria, followed by subsequent bacterial metastasis, allowing the infection to spread to other bodily regions, which leads to different clinical signs depending on: the virulence of the salmonella strain, the organs affected, the animal species, as well as the age and immune status of the host (Robert et al., 2013; Gruenberg, 2018). Theileriosis is one of the most fatal TBD of animals caused by different Theileria spp. The parasite induces lymphohematopathies resulting in fever, anorexia, immunosuppression, body depletion, hemorrhagic anemia and, in some rare cases, hemolytic anemia with hematuria. Pathogenesis and clinical signs of the disease in camels are not well characterized; however, documented clinical and subclinical cases have not previously reported signs of hematuria or hemoglobinuria (Magda et al., 1998; Hamed et al., 2011; Hekmatimoghaddam et al., 2012). Clinical signs including fever, anorexia, swelling of superficial lymph nodes, rapid loss of body condition, lacrimation, abortion, infertility, intermittent diarrhea, and nervous signs have been reported in camels. Clinical pathology profiles with marked lymphopenia, anemia, hypoproteinemia, increased blood levels of gammaglutamyl transferase (GGT), aspartateaminotransferase (AST), alanine aminotransferase (ALT), total bilirubin, blood urea nitrogen, lactate dehydrogenase (LDH), and the cytokines interleukin-4 (IL-4) and interleukin-10 (IL-10) have also been observed in affected camels (El-Fayoumy et al., 2005; Hamed et al., 2011; Ismael et al., 2014; El-Naga and Barghash, 2016). Incidence of clinical theileriosis in camels is yet to be reported in the United Arab Emirates (UAE); However, Theileria annulata antigen has been detected in Hyalomma dromedarii ticks in the Eastern region of the Abu Dhabi emirate (Al-Deeb et al., 2015). Hematuria is a clinical phenomenon associated with acute renal and lower urinary tract inflammations, traumatic calculous injuries, cancers, or corrosive poisonings (Rachel and Charles, 2016). Chronic camel hematuria with undetermined etiology has been reported, however, attempts to isolate and identify any etiological agent associated with the clinical symptoms have thus far failed (Bhandare, 2009). In this study, we report the isolation and characterization of a known bacterial pathogen from two camels, which tested positive for theileriosis and showed clinical symptoms of acute febrile disease with hematuria and discuss the implications of these novel findings. Materials and MethodsStudy casesSamples were taken from two young racing camels of the Omani breed, approximately 2 years of age, which were housed with 50 other animals in a semi-closed farm system in Madinat Zayed, in the Al Dhafra Region, UAE. The samples were taken during a routine field follow up by a qualified ADAFSA veterinarian during the month of October 2016. Both animals exhibited acute clinical disturbances including fever, anorexia, excretion of red urine, and progressive loss of body weight. The two animals were infested with ticks; however, tick identification was not attempted. Samples collectionBloody urine samples were collected directly from the animals during urine flow in sterile urine containers, taking care not to contaminate the container, and samples were immediately submitted to the regional laboratory for microscopic examination, bacterial culturing, and subsequent antibiotic sensitivity testing of the recovered isolates. Blood samples were also collected from the jugular vein of the affected animals using 1) plain vacutainer tubes and 2) EDTA—containing vacutainer tubes. The plain vacutainer tubes were left at room temperature for 12 hours to allow clotting. The separated sera were stored at –40°C until tested. Blood and serum samples were investigated for hematology and chemistry profile according to Thrall et al. (2012). Parasitological investigationBlood parasite analysis was conducted by preparing thin blood films, which were subsequently fixed and stained with Giemsa stain, following the methods described by Morrison (2015, 2018). Bacteriological examinationCulturing under aerobic and anaerobic conditions, purification, and isolation of bacteria were done according to the standard microbiology culture procedures (Songer and Post, 2005). Isolation of Salmonella spp. was done following the standards set out according to ISO (6579-1:2017). Biochemical identification of the isolates was done using the API 20 E—Biomerieux and Vitek II identification systems. For quality control assays, oxidase and catalase test positive controls of “Pseudomonas aeruginosa ATCC 27853 and Staphylococcus aureus ATCC 25923” and negative controls of “Escherichia coli ATCC 25922 and Enterococcus faecalis ATCC 29212” were incorporated. A serological slide agglutination test for the presence of Salmonella polyvalent somatic O A-I+VI antisera was used. Reference Salmonella typhimurium (ATCC 14028) was incorporated as a control positive and 0.85% Sodium Chloride as a control negative. Antibiotic sensitivity testing using the disc diffusion method on Muller–Hinton Agar was followed to examine sensitivity reactions of the isolated bacteria against Enrofloxacin (5 μg), Tetracycline (30 μg), Ampicillin (10 μg) Penicillin (10U), and Cotrimoxazole (Trimethoprim + Sulfamethoxazole 1.25/23.75 μg). Escherichia coli ATCC 25922 was used as a positive control according to the Clinical and Laboratory Standards Institute (CLSI, 2018). DNA extraction and amplificationDNA extraction was done from a pure culture of the isolates (n=2 per sample extraction), by incubating the samples in 200 μl of buffer ATL (Qiagen, Hilden, Germany) containing 2 mg of lysozyme (from hen egg white, Roche, Switzerland) for 30 minutes at 37°C, followed by the addition of 20 μl of proteinase K and a further incubation at 56¼C for 30 minutes. DNA was isolated using the DNeasy Blood and Tissue kit (Qiagen, Hilden, Germany), following the manufacturer’s instructions. DNA purity and yield were measured on a nanodrop 2000 spectrophotometer (ThermoScientific, USA). PCR was done to amplify part of the bacterial 16S ribosomal RNA gene using the universal primer sets 27F (5’-AGA GTT TGA TCC TGG CTC AG-3’) and 907R (5’-CCC CGT CAA TTC ATT TGA GTT T-3’) to generate an amplicon around 900–950 bp in length (Lane, 1991; Muyzer and Smalla, 1998). The PCR-thermal profile was set to 95°C for 10 minutes for initial denaturation and activation of the polymerase (Amplitaq Gold 360, Applied Biosystems, USA), 40 cycles of 94 ¼C for 30 seconds, 54¼C for 30 seconds, and 72 °C for 1 minute, followed by a final hold at 72¼C for 7 minutes. The amplicons were visualized on a 2% agarose gel. Sanger sequencingFor preparation of DNA sequencing, the PCR amplicons were purified using the Qiagen PCR purification kit (Qiagen, Hilden, Germany) and 1 μl of purified amplicon was sequenced using the BigDye terminator 3.1 sequencing kit (Applied Biosystems, USA) in a 10 μl reaction, following the manufacturer’s guidelines for primer concentration and thermal cycling. Sequencing reactions were purified using the DyeEx™ spin kit (Qiagen, Hilden, Germany), and sequenced on a 3130-genetic analyzer (Applied Biosystems, USA) fitted with a 36 cm column filled with POP-7 polymer (Applied Biosystems, USA). BioinformaticsPost-processing of the sequencing chromatograms was performed in Sequencing Analysis 5.2 software (Applied Biosystems, USA) using the default “3130POP7_BDTv3-KB-Devnovo_v5.2” analysis protocol to remove low-quality sequence read ends. Forward and reverse sequences were aligned using ClustalW in MEGA 7 software (Kumar et al., 2016), and the consensus sequence was subjected to a blast search of the NCBI RefSeq genome database. Visualizations of the reads mapped against the closest matching genome were created in Unipro UGENE (Okonechnikov et al., 2012). Ethical approvalAll animal handling procedures were in accordance with the Regulations of the standard animal’s regulation care. ResultsClinical and microscopic examinationClinical examination of sick animals demonstrated acute clinical signs of hyperthermia (38°C–39°C), anorexia, progressive body depletion, homogenous red urine indicative of hematuria (Fig. 1), and an unfavorable prognosis upon the onset of severe anemia. Centrifugation of the urine samples revealed sedimentation of red blood cells at the bottom of the test tubes which confirmed hematuria. At the same time, homogenization of urine with blood indicated the renal origin of the hemorrhage. A complete blood count illustrated severe reductions in the total red blood cell count and other blood indices, while chemical blood profiling illustrated non-significant alterations rates in comparison to standard camel hematology parameters. Parasitological examination of Giemsa stained blood films demonstrated pleomorphic intraerythrocytic Theileria piroplasms (Fig. 2). Isolation, identification and sensitivity testingAfter 24 hours of incubation at 37°C under aerobic and anaerobic conditions, pure non-lactose fermented bacterial colonies were observed on MacConkey agar, H2S production at XLD agar media and red to pink colonies with reddening of the media on Brilliant Green agar (Fig. 3). The isolates were also recovered from Rappaport–Vassiliadis after incubation for 48 hours at 41.5°C. Microscopic examination of Gram-stained smears from both cultures revealed a Gram-negative rod-shaped bacterium, which reacted positive for catalase and negative for oxidase. Further identification using the Vitek II full identification system identified the isolates as Salmonella enterica subsp. enterica with a 90% confidence score. Antibiotic sensitivity testing showed that the isolates were sensitive to Cotrimoxazole and Enrofloxacin (5 μg) and resistant to Tetracycline (30 μg), Ampicillin (10 μg), and Penicillin (10 U).
Fig. 1. (A) Clinically infected dromedary camel excreting red urine. (B) Red urine sample collected from the animal.
Fig. 2. Blood film from infected dromedary camel shows intraerythrocytic pleomorphic Theileria piroplasms (arrows) (Giemsa stain, 100×).
Fig. 3. Cultures of isolated salmonella from the red urine. (A) H2S production reaction on XLD medium; (B) non-lactose fermentation growth on MAC agar medium; (C) chromogenic reduction reaction (red to green) on brilliant green agar medium; and (D) API biochemical identification reaction. Molecular resultsA consensus sequence of 905 bp was generated for both samples. The blast search revealed a 100% identity coverage match of both sequences to the reference sequence of Salmonella enterica subsp. enterica serovar Typhimurium strain LT2. Both sequences mapped to the genome at regions 3571087–3571991 (Figs. 4 and 5). DiscussionDespite a global growth in husbandry, camel diseases remain relatively poorly characterized. Animal salmonellosis is one of the most important diseases of public health globally, due to the pathogen’s potential to infect humans. In this study, the isolation of Salmonella enterica subsp. enterica serovar Typhimurium from febrile camels with hematuria is remarkable because previous studies indicated that camel urine has inhibitory effects against some bacteria (Shoeib and Ba-hatheq, 2007; Humaid, 2016). However, our results corroborated findings by Allerberger et al. (1992) who found nontyphoidal Salmonella spp. as a causative agent of urinary tract infection in human. Despite reports of theileriosis in camels elsewhere, to date, no clinical cases of the disease have been reported in UAE. However, T. annulata antigen was detected in the tick vector; H. dromedarii in Al Ain, in the eastern region of Abu Dhabi. Previous studies stated that fever, anorexia, swelling of superficial lymph nodes, rapid loss of body weight, lacrimation, abortion, infertility, intermittent diarrhea, and nervous signs were common clinical signs of the disease in camels, as well in other hosts (El-Fayoumy et al., 2005; Hamed et al., 2011; Ismael et al., 2014; El-Naga and Barghash, 2016). A pathological profile marked by lymphopenia, anemia, hypoproteinemia, increased GGT, AST, ALT, Total bilirubin, blood urea nitrogen, LDH, and cytokines IL-4 and IL-10 blood levels were also found (El-Fayoumy et al., 2005; Hamed et al., 2011; Ismael et al., 2014). According to the pathogenesis of theileriosis, no symptoms of hematuria or hemoglobinuria have been observed in any susceptible animal host (Hamed et al., 2011; Hekmatimoghaddam et al., 2012). In contrast to these findings, we noticed a completely homogenized hematuria in two dromedary camels infected with Theileria piroplasms, as determined by microscope observation. Pathologically, the Theileria parasite is known to induce immunosuppression due to lymphoid tissue depletion which may encourage the propagation of opportunistic bacterial growth as a secondary consequence (Morrison, 2015). However, exclusive invasion of the urinary tract by Salmonella enterica subsp. enterica serovar Typhimurium out of the huge number of potential opportunistic bacteria within a camel is a notable finding. The hematological parameters, which indicated severe macrocytic hypochromic anemia reported in this study, were likely the result of severe blood loss, followed by an accelerated response of erythropoiesis. Pathogenesis of lymphopenia and eosinophilia recorded in this study were indicative of lymphadenopathies induced by the Theileria parasite which initially proliferates in the lymphoid tissue resulting in lymphocytopenia (Morrison, 2015; 2018). On the other hand, neutrophilia could be the result of the isolation of salmonella from this case. Finally, the association of hematuria with Salmonella and Theileria coinfection in this study is reported for the first time and further pathological investigations in the field of camel diseases are recommended. Animals in nature are commonly co-infected by two or more different pathogens or strains which may act independently or interact with one another and with the host through various mechanisms. Despite the limited number of studies, it has been hypothesized that parasites, including Schistosoma spp., Plasmodium spp., and helminthes lead to various changes in organs that increase the susceptibility of animals to salmonella infections (Sümer et al., 2014; Hsiao et al., 2016; Reynolds et al., 2017). This may also be true in dual Theileria and Salmonella enterica infection in camels, particularly its impact on diagnosis, treatment, and prevention. Highlights
Fig. 4. Mapping of the sample 1 sequence reads to the reference genome of Salmonella enterica subsp. enterica serovar Typhimurium str. LT2. All four sequence reads mapped with 100% identity, spanning a total length of 905 bp between positions 3571087 and 3571991.
Fig. 5. Mapping of the sample 2 sequence reads to the reference genome of Salmonella enterica subsp. enterica serovar Typhimurium str. LT2. All four sequence reads mapped with 100% identity, spanning a total length of 905 bp between positions 3571087 and 3571991. AcknowledgmentThe authors would like to thank Miss Asma Abdi Shah, Manager of Pathology & Sample Management Section for her administrative assistance and co-operation in the achievement of this work. Conflict of interestThe authors certify that there is no conflict of interest. Authors’ contributionJamal Fattah Rifat contributed to sampling and providing of epidemiological data. Ghada Elderdiri Abdelwahab and El Tigani-Asil Ahmed El Tigani substantially contributed to conception and design of the study, laboratory analysis, interpretation of microbiological data, and drafted the manuscript. Mohammed Farouk Yusof and Zayed Saud Abdalla contributed to sequencing and bioinformatic analysis. Abdelmalik Ibrahim Khalafalla and Mohamed A. Al Hosani critically revised the manuscript. Salama Suhail Mohammed Al Muhairi has read and approved the final version of the manuscript. ReferencesAbbas, B. and Omer, O.H. 2005. Review of infectious diseases of camel. Vet. Bull. 75(8), 1N–16N. Al-Deeb, M.A., Bin Muzaffar, S., Abu-Zeid, Y.A., Enan, M.R. and Karim, S. 2015. First record of a spotted fever group Rickettsia sp. and Theileria annulata in Hyalomma dromedarii (Acri: Ixodidae) ticks in the United Arab Emirates. Fla Entomol. 98(1), 135–139. Allerberger, F.J., Dierich, M.P., Ebner, A., Keating, M.R., Stechelberg, J.M., Yu, P.K. and Anhalt, J.P. 1992. Urinary tract infection by Nontyphoidal salmonella: report of 30 cases. Urol. Int. 48(4), 395–400. Allison, R.W. and Meinkoth, J.H. 2010. Anemia caused by Rickettsia, mycoplasma and protozoa. In Schalm’s veterinary hematology, 6th ed. Eds., Weiss, D.J. and Wardrop, K.J. Hoboken, NJ: Wiley-Blackwell. Bhandare, S.G. 2009. Chronic hematuria in Camel: A case report. Vet. World 2(4), 148. Clinical and Laboratory Standards Institute (CLSI). 2018. Performance Standards for Antimicrobial Disk and Dilution Susceptibility Test for Bacteria Isolated from Animals; Approved Standard, 5th ed. VET01 and Second Information Supplemental Tables VET08. El-Fayoumy, M.M., Abou Elnga, T.R., Abd El-Baky, S.M.M. and Abdou, T.A. 2005. Prevalence of camel theileriosis and its vector tick in north coast of Egypt. J. Egypt. Vet. Med. Assoc. 65, 291–302. El-Naga, T.R.A. and Barghash, S.M. 2016. Blood Parasites in Camels (Camelus dromedarius) in North West coast of Egypt. J. Bacteriol. Parasitol. 7, 258. Gordon, M.A. 2008. Salmonella infections in immunocompromised adults. J. Infect. 56(6), 413–422. Gruenberg, W. 2018. Overview of Salmonellosis in Merck Sharp & Dohme Veterinary Manual. Kenilworth, NJ: Merck Sharp & Dohme Corp., a subsidiary of Merck & Co., Inc. Hamed, M.I., Zaitoun, A.M.A., El – Allawy, T.A.A. and Mourad, M.I. 2011. Investigation of Theileria camelenses in camels infested by Hyalomma dromedarii tick in upper Egypt. J. Adv. Vet. Res. 1, 4–7. Hekmatimoghaddam, S., Sazmand, A., Rasooli, A., Hamidinejat, H. and Jafari, H. 2012. Laboratory tests in dromedary camels naturally infected with piroplasms in Iran. Study and review of literature. J. Camel Pract. Res. 19(2), 217–221. Hsiao, A., Toy, T., Seo, H.J. and Marks, F. 2016. Interaction between Salmonella and Schistosomiasis: A Review. PLoS Pathog. 12(12), e1005928. Humaid, A.A. 2016. Antagonistic effect of camel’s urine on some pathogenic bacterial species. PSM Vet. Res. 1(1), 8–12. Ismael, A.B., Swelum, A.A., Khalaf, A.F. and Abouheif, M.A. 2014. Clinical, hematological and biochemical alterations associated with an outbreak of theileriosis in dromedaries (Camelus dromedaries) in Saudi Arabia. Pak. Vet. J. 34(2), 209–213. ISO 6579-1. 2017. Microbiology of the food chain—horizontal method for the detection, enumeration and serotyping of Salmonella. Part 1 Detection of Salmonella spp. Geneva, Switzerland: International Standard Organization. Rachel, E.C. and Charles, F.M. 2016. Urinary system. In Jubb, K.V.F. PC. Kennedy, and NC Palmer’s pathology of domestic animals, 6th ed. Eds., Grant Maxie, M.. St. Louis (Missouri): Elsevier, cop., pp: 376–464. Kumar, S., Stecher, G. and Tamura, K. 2016. MEGA 7: molecular evolutionary genetics analysis version 7.0 for bigger datasets. Mol. Biol. Evol. 33, 1870–1874. Lane, D.J. 1991. 16S/23S rRNA sequencing. In Nucleic acid techniques in bacterial systematics. Eds., Stackebrandt, E. and Goodfellow, M. New York: John Wiley and Sons, pp: 115–175. Magda, A.H.E., Wahba, A.A. and Shehab, G.J. 1998. Studies on Theileria infection among slaughtered camels in Egypt. Egypt. J. Med. Sci. 19(1), 1–17. Mohamed, M.E.M. and Suelam, I.I.A. 2010. Isolation of non-typhoid salmonella from humans and camels with references to its survival in abattoirs effluents. Glob. Vet. 5(6), 356–361. Morrison, W.I. 2015. The aetiology, pathogenesis and control of theileriosis in domestic animals. Rev. Sci. Tech. 34(2), 599–611. Morrison, W.I. 2018. Theileriosis. Merck Veterinery Manual. Kenilworth, NJ: Merck Sharp & Dohme Corp., a subsidiary of Merck & Co., Inc. Muyzer, G. and Smalla, K. 1998. Application of denaturing gradient gel electrophoresis (DGGE) and temperature gradient gel electrophoresis (TGGE) in microbial ecology. Antonie Van Leeuwenhoek 73(1), 127–141. Okonechnikov, K., Golosova, O., Fursoy, M. and UGENE team. 2012. Unipro UGENE: a unified bioinformatics toolkit. Bioinformatics 28, 1166–1167. Reynolds, L.A., Redpath, S.A., Yurist-Doutsch, S., Gill, N., Brown, E.M., van der Heijden, J., Brosschot, T.P., Han, J., Marshall, N.C., Woodward, S.E., Valdez, Y., Borchers, C.H., Perona-Wright, G. and Finlay, B.B. 2017. Enteric Helminths Promote Salmonella Coinfection by Altering the Intestinal Metabolome. J. Infect. Dis. 215(8), 1245–1254. Robert, T.S.W., Winter, C.S.E. and Baumler, A.J. 2013. Salmonella virulence mechanisms and their genetic basis. In Salmonella in domestic animals, 2nd ed. Eds., Barrow, P.A. and Methner, U. www.cabi.org. Shoeib, A. and Ba-hatheq, A. 2007. Effect of camel’s urine on pathogenic Pseudomonas aeruginosa and E. coli isolates towards its maintains to their antibiotic (s) resistance and the presence of plasmid(s). Saudi J. Biol. Sci. 14(2), 177–184. Songer, J.G. and Post, K.W. 2005. Veterinary microbiology: bacterial and fungal agents of animal disease, 1st ed. St, Louis, MO: Saunders. Sümer, S., Ural, G. and Ural, O. 2014. Plasmodium falciparum and Salmonella Typhi co-infection: a case report. Mikrobiyol Bul. 48(1), 174–178. Thrall, M.A., Weiser, G., Allison, R. and Campbell, T. 2012. Veterinery hematology and clinical chemistry, 2nd ed. Hoboken, NJ: Wiley-Blackwell. Yagoub, S.O. 2005. Bacterial disease of the reproductive system of camels (Camelus dromedaries) in Eastern Sudan. J. Anim. Vet. Adv. 4(7), 642–644. | ||
| How to Cite this Article |
| Pubmed Style Abdelwahab GE, , Yusof MF, Abdullah ZS, Rifat JF, , Almuhairi SS, Khalafalla AI. Salmonella enterica and Theileria co-infection in dromedary camels (Camelus dromedarius) in UAE. Open Vet. J.. 2019; 9(3): 263-268. doi:10.4314/ovj.v9i3.12 Web Style Abdelwahab GE, , Yusof MF, Abdullah ZS, Rifat JF, , Almuhairi SS, Khalafalla AI. Salmonella enterica and Theileria co-infection in dromedary camels (Camelus dromedarius) in UAE. https://www.openveterinaryjournal.com/?mno=50623 [Access: January 25, 2026]. doi:10.4314/ovj.v9i3.12 AMA (American Medical Association) Style Abdelwahab GE, , Yusof MF, Abdullah ZS, Rifat JF, , Almuhairi SS, Khalafalla AI. Salmonella enterica and Theileria co-infection in dromedary camels (Camelus dromedarius) in UAE. Open Vet. J.. 2019; 9(3): 263-268. doi:10.4314/ovj.v9i3.12 Vancouver/ICMJE Style Abdelwahab GE, , Yusof MF, Abdullah ZS, Rifat JF, , Almuhairi SS, Khalafalla AI. Salmonella enterica and Theileria co-infection in dromedary camels (Camelus dromedarius) in UAE. Open Vet. J.. (2019), [cited January 25, 2026]; 9(3): 263-268. doi:10.4314/ovj.v9i3.12 Harvard Style Abdelwahab, G. E., , Yusof, . M. F., Abdullah, . Z. S., Rifat, . J. . F. ., , Almuhairi, . S. S. & Khalafalla, . A. I. (2019) Salmonella enterica and Theileria co-infection in dromedary camels (Camelus dromedarius) in UAE. Open Vet. J., 9 (3), 263-268. doi:10.4314/ovj.v9i3.12 Turabian Style Abdelwahab, Ghada Elderdiri, El Tigani Ahmed El Tigani Asil, Mohammed Farouk Yusof, Zayed Saud Abdullah, Jamal Fattah Rifat, Mohamed A. Al Hosani, Salama Suhail Almuhairi, and Abdelmalik Ibrahim Khalafalla. 2019. Salmonella enterica and Theileria co-infection in dromedary camels (Camelus dromedarius) in UAE. Open Veterinary Journal, 9 (3), 263-268. doi:10.4314/ovj.v9i3.12 Chicago Style Abdelwahab, Ghada Elderdiri, El Tigani Ahmed El Tigani Asil, Mohammed Farouk Yusof, Zayed Saud Abdullah, Jamal Fattah Rifat, Mohamed A. Al Hosani, Salama Suhail Almuhairi, and Abdelmalik Ibrahim Khalafalla. "Salmonella enterica and Theileria co-infection in dromedary camels (Camelus dromedarius) in UAE." Open Veterinary Journal 9 (2019), 263-268. doi:10.4314/ovj.v9i3.12 MLA (The Modern Language Association) Style Abdelwahab, Ghada Elderdiri, El Tigani Ahmed El Tigani Asil, Mohammed Farouk Yusof, Zayed Saud Abdullah, Jamal Fattah Rifat, Mohamed A. Al Hosani, Salama Suhail Almuhairi, and Abdelmalik Ibrahim Khalafalla. "Salmonella enterica and Theileria co-infection in dromedary camels (Camelus dromedarius) in UAE." Open Veterinary Journal 9.3 (2019), 263-268. Print. doi:10.4314/ovj.v9i3.12 APA (American Psychological Association) Style Abdelwahab, G. E., , Yusof, . M. F., Abdullah, . Z. S., Rifat, . J. . F. ., , Almuhairi, . S. S. & Khalafalla, . A. I. (2019) Salmonella enterica and Theileria co-infection in dromedary camels (Camelus dromedarius) in UAE. Open Veterinary Journal, 9 (3), 263-268. doi:10.4314/ovj.v9i3.12 |